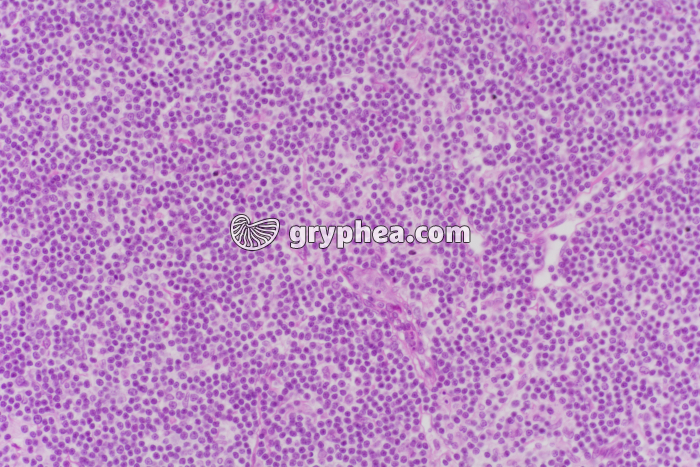
Thymus x40 - gryphea.org

Les photographies, infographies, vidéos, sons et textes publiés sur ce site ne sont pas totalement libres de droits. Vous pouvez les utiliser librement à titre personnel, dans la création de vos cours, compte-rendus, diaporamas, en respectant le watermark qui y est inclus, à la condition expresse d'avoir souscrit à un abonnement. Le contrat d’utilisation ne vous autorise cependant pas à diffuser ces documents ailleurs que dans le cadre strict de votre enseignement, et en aucun cas sur les réseaux sociaux. Merci de votre compréhension.
Pour accéder à tous les contenus de gryphea.org, aux photos haute définition et aux vidéos intégrales, profitez de nos offres d'abonnement :
Le thymus est un organe lymphoïde primaire, de petite taille (15 à 25g en moyenne chez l’enfant), formé de 2 lobes, et localisé à la limite entre le cou et le thorax, juste sous la thyroïde. Il atteint son maximum de développement au cours de la puberté, puis régresse imperceptiblement durant toute la vie d’adulte, pour disparaître presque complètement chez les vieillards. Cet un organe qui joue un rôle primordial dans la maturation de certaines cellules immunitaires originaires de la moelle osseuse, les lymphocytes T, qui acquièrent des récepteurs membranaires nouveaux lors de leur séjour dans l’organe.
Note : Chez le veau, le thymus, hypertrophié par rapport à celui de l’Homme, est proposé comme mets d’exception appelé «ris de veau».
La suite du commentaire est réservée aux abonnés